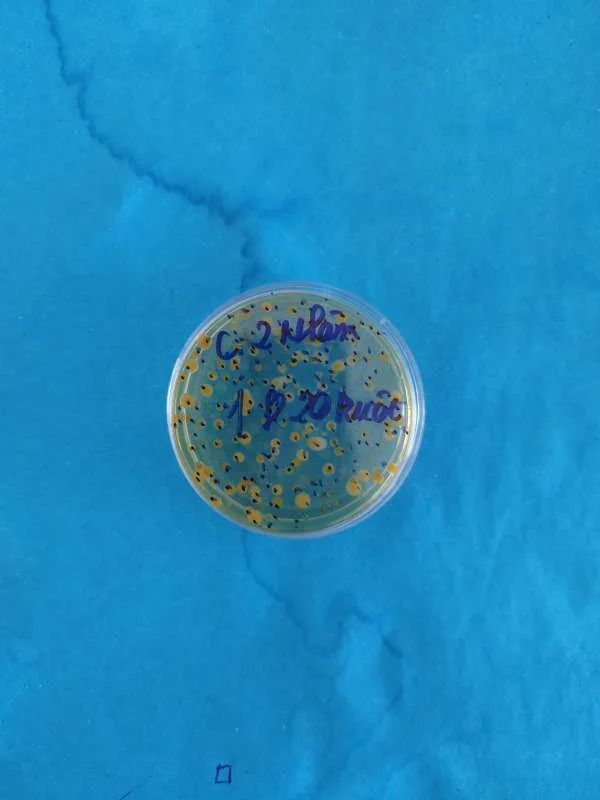
Kiểm Soát Vi Khuẩn Trong Ao Tôm Nuôi: Chiến Lược Toàn Diện Và Hiệu Quả

Chăm Sóc Ao Nuôi Tôm: Cách Ngăn Chặn Hiện Tượng Bám Bờ Vào Ban Đêm
Hiện tượng tôm bám bờ vào ban đêm là một trong những vấn đề phổ biến trong nuôi tôm, gây thiệt hại lớn về năng suất và kinh tế cho người nuôi. Để giải quyết triệt để hiện tượng này, chúng ta cần hiểu rõ nguyên nhân và áp dụng các biện pháp xử lý hiệu quả. Dưới đây là một bài viết chi tiết về cách xử lý hiện tượng tôm bám bờ vào ban đêm:
1. Hiểu rõ nguyên nhân tôm bám bờ
Tôm bám bờ vào ban đêm có thể do nhiều nguyên nhân, trong đó có thể kể đến:
Chất lượng nước kém: Hàm lượng oxy hòa tan thấp, độ pH không ổn định, nồng độ các chất độc hại cao như NH3, NO2, H2S.
Thiếu oxy: Vào ban đêm, thực vật thủy sinh và tảo sẽ tiêu thụ oxy cho quá trình hô hấp, dẫn đến thiếu oxy hòa tan trong nước
Tảo tàn: Khi tảo trong ao phát triển quá mức và tàn, chúng phân hủy và tiêu thụ một lượng lớn oxy, đồng thời giải phóng các chất độc hại.
Dịch bệnh: Một số bệnh do vi khuẩn, virus hoặc ký sinh trùng có thể khiến tôm bị suy yếu, làm cho chúng phải di chuyển lên bờ để tìm kiếm môi trường sống tốt hơn.
Thức ăn kém chất lượng: Thức ăn không đảm bảo chất lượng hoặc không đủ dinh dưỡng có thể làm cho tôm suy dinh dưỡng và dễ mắc bệnh.
Môi trường sống không phù hợp: Quá trình phát triển không đồng đều của đáy ao, sự hiện diện của bùn, cặn bã hữu cơ có thể ảnh hưởng đến môi trường sống của tôm.
2. Các biện pháp xử lý hiện tượng tôm bám bờ vào ban đêm
Quản lý chất lượng nước
Đảm bảo hàm lượng oxy hòa tan (DO): Sử dụng máy sục khí hoặc máy quạt nước để cung cấp oxy cho ao nuôi. Kiểm tra hàm lượng oxy thường xuyên, đặc biệt vào ban đêm và sáng sớm. Hàm lượng oxy hòa tan cần duy trì ở mức 4-6 mg/L.
Kiểm soát độ pH: Độ pH của nước ao nên duy trì trong khoảng 7.5-8.5. Sử dụng vôi nông nghiệp (CaCO3) hoặc các chất điều chỉnh pH khác để ổn định pH.
Giảm nồng độ các chất độc hại: Sử dụng chế phẩm sinh học để phân giải các chất hữu cơ trong ao, giảm thiểu nồng độ NH3, NO2 và H2S. Định kỳ thay nước để loại bỏ các chất cặn bã.
Kiểm soát sự phát triển của tảo
Quản lý lượng dinh dưỡng: Hạn chế lượng phân bón và thức ăn dư thừa, tránh hiện tượng phú dưỡng hóa nước ao.
Sử dụng chế phẩm sinh học: Các chế phẩm sinh học có thể giúp kiểm soát sự phát triển của tảo bằng cách cạnh tranh nguồn dinh dưỡng với tảo hoặc tiêu diệt tảo.
Thay nước định kỳ: Thay nước một cách hợp lý để loại bỏ bớt tảo và các chất cặn bã.
Phòng và trị bệnh cho tôm
Quản lý sức khỏe tôm: Thường xuyên kiểm tra sức khỏe tôm, quan sát biểu hiện bên ngoài và hành vi của tôm để phát hiện sớm các dấu hiệu bệnh tật.
Sử dụng thuốc và hóa chất hợp lý: Sử dụng các loại thuốc và hóa chất được phép và theo hướng dẫn của chuyên gia để điều trị bệnh cho tôm. Tránh lạm dụng thuốc kháng sinh để không gây kháng thuốc và ảnh hưởng xấu đến môi trường
Cải thiện dinh dưỡng: Đảm bảo cung cấp thức ăn chất lượng cao, giàu dinh dưỡng và phù hợp với từng giai đoạn phát triển của tôm.
Cải tạo môi trường ao nuôi
Xử lý đáy ao: Trước khi thả tôm, cần xử lý đáy ao kỹ lưỡng bằng cách phơi khô, bón vôi và loại bỏ bùn đáy. Điều này giúp giảm thiểu sự phát triển của vi khuẩn có hại và cải thiện chất lượng nước.
Sử dụng chế phẩm sinh học: Các chế phẩm sinh học giúp phân hủy chất hữu cơ trong ao, tạo môi trường sống lành mạnh cho tôm.
Quản lý bùn đáy: Định kỳ hút bùn đáy để loại bỏ cặn bã hữu cơ và các chất độc hại tích tụ.
Áp dụng kỹ thuật nuôi tiên tiến
Nuôi ghép tôm cá: Kết hợp nuôi tôm với các loài cá như cá rô phi, cá chép để kiểm soát tảo và cặn bã hữu cơ trong ao.
Sử dụng hệ thống lọc sinh học: Hệ thống lọc sinh học giúp duy trì chất lượng nước tốt hơn bằng cách loại bỏ các chất cặn bã và chất độc hại.
3. Các biện pháp dự phòng
Lập kế hoạch nuôi hợp lý
Lựa chọn thời điểm thả tôm: Thả tôm vào thời điểm thích hợp để tránh những giai đoạn thời tiết khắc nghiệt hoặc những giai đoạn tảo phát triển mạnh.
Điều chỉnh mật độ nuôi: Mật độ nuôi tôm cần được điều chỉnh phù hợp với diện tích và điều kiện môi trường của ao nuôi để tránh quá tải, gây ra các vấn đề về chất lượng nước và sức khỏe tôm.
4. Kết luận
Xử lý hiện tượng tôm bám bờ vào ban đêm không phải là một công việc đơn giản, đòi hỏi sự hiểu biết sâu sắc về nguyên nhân gây ra hiện tượng này cũng như áp dụng các biện pháp kỹ thuật phù hợp. Việc quản lý chất lượng nước, kiểm soát tảo, phòng và trị bệnh, cải tạo môi trường ao nuôi và áp dụng các kỹ thuật nuôi tiên tiến là những yếu tố then chốt để giải quyết vấn đề này. Đồng thời, người nuôi cần lập kế hoạch nuôi hợp lý và thường xuyên nâng cao kiến thức để có thể ứng phó kịp thời với các tình huống phát sinh, đảm bảo sự phát triển bền vững của nghề nuôi tôm.